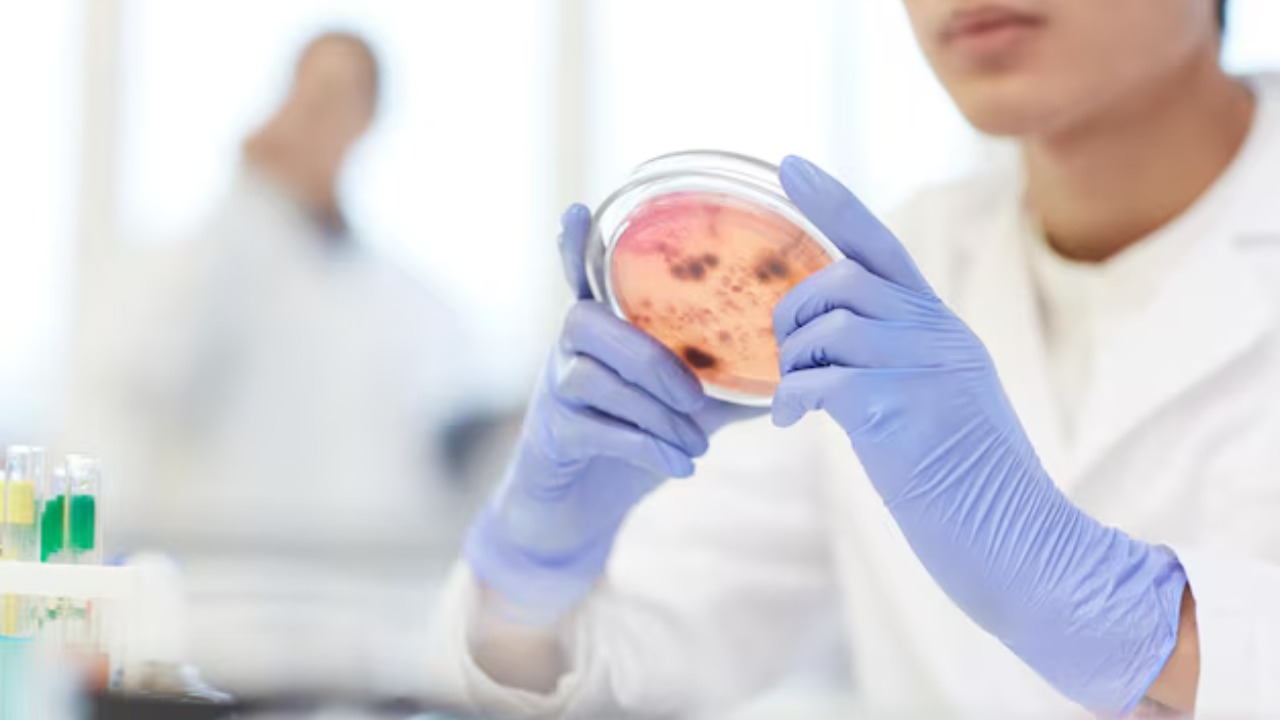
Image by Freepik

Researchers have identified a promising new molecule in the venom of an Amazonian scorpion that has shown potential to kill breast cancer cells in laboratory tests. This groundbreaking discovery could pave the way for innovative cancer treatments, harnessing the unique properties of venom that have been largely unexplored in medical research.
The Discovery of the Molecule

Identifying and isolating the specific compound within the venom of the Amazonian scorpion was a meticulous process. Scientists employed advanced biochemical techniques to separate the active molecule responsible for targeting cancer cells. The research team focused on understanding the complexities of the venom’s composition to pinpoint the exact compound with therapeutic potential.
This discovery was made possible through extensive collaborative efforts. The project brought together biochemists, oncologists, and toxicologists, each contributing their expertise to unravel the mysteries of scorpion venom. This interdisciplinary approach was crucial, highlighting the importance of combining diverse scientific perspectives to achieve breakthroughs in medical research.
Mechanism of Action

The molecule discovered in the scorpion venom works by uniquely targeting and killing breast cancer cells. Researchers have observed that it disrupts specific cellular processes, leading to the destruction of cancerous cells while leaving healthy ones unharmed. This precision in action is a significant advantage, as it minimizes collateral damage to normal cells, a common issue with many current cancer treatments.
One of the most remarkable aspects of this compound is its selectivity and precision. Unlike traditional therapies that can affect both cancerous and healthy cells, this molecule seems to specifically target the malignant ones. This targeted approach is a promising development, potentially leading to treatments with fewer adverse effects and more effective outcomes.
Potential Advantages Over Existing Treatments

One of the most promising aspects of this venom-based treatment is the potential for reduced side effects. Traditional chemotherapy often leads to a range of unpleasant and sometimes severe side effects due to its non-selective nature. In contrast, the scorpion venom-derived compound promises a more targeted attack on cancer cells, potentially sparing patients from the typical side effects of chemotherapy.
Moreover, the enhanced efficacy of this treatment could offer new hope for breast cancer patients. By combining this novel treatment with existing therapies, there is potential to improve patient outcomes significantly. This combination approach could lead to more comprehensive treatment strategies, increasing the chances of remission and recovery.
Challenges and Future Research

Despite the promising results, several challenges remain before this treatment can become widely available. One significant hurdle is scaling and synthesis, as replicating and mass-producing the molecule for clinical trials requires further research and development. Scientists are working on methods to synthesize the molecule efficiently, ensuring a stable supply for future studies and eventual therapeutic use.
Additionally, regulatory and ethical considerations must be addressed. Navigating the pathway from laboratory discovery to an approved treatment involves rigorous testing and adherence to safety standards. Researchers must ensure that the benefits of this new treatment outweigh any potential risks, securing approval from regulatory bodies.
Broader Implications for Cancer Research
The discovery of a cancer-fighting compound in scorpion venom opens exciting new possibilities for cancer research. It suggests that other venomous creatures might also harbor compounds with similar therapeutic potential. This realization could lead to a broader exploration of venom-derived compounds, expanding the horizons of cancer treatment options.
Beyond cancer treatment, new avenues in drug development might emerge from this research. The pharmaceutical industry could see a shift towards exploring natural toxins and venoms as sources of novel therapies, not just for cancer but for a variety of diseases. This innovative approach holds the potential to revolutionize how we develop medications, offering new hope for tackling some of the most challenging health issues.
